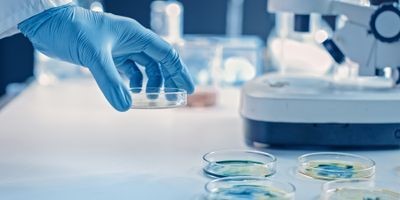

Các nhà khoa học thiết kế Enzyme vi khuẩn được cho là có khả năng ngăn chặn phản ứng miễn dịch
TNNN - Enzyme vi khuẩn được gọi là Lit bị nghi ngờ có vai trò "tàng hình" trong việc giảm phản ứng miễn dịch.
- Chương trình VPT.2.5.20.297 - Chất lượng phân bón silicat kiềm
- Phát hiện mới về thuốc phòng ngừa HIV
- Thử nghiệm Ngày nay số 28
- Đẩy mạnh đầu tư nhằm nâng cao năng lực chế biến rau quả
Các nhà khoa học đã tạo ra bản thiết kế phân tử chi tiết đầu tiên về một loại enzyme vi khuẩn được gọi là Lit, với hoài nghi có vai trò "tàng hình" sự tiến triển của nhiễm trùng bằng cách giảm phản ứng miễn dịch.
Các bản thiết kế như vậy cho phép các nhà y dược phát hiện ra những điểm yếu tiềm ẩn trong các vi khuẩn khi họ tìm cách phát triển các phương pháp điều trị mới có thể giúp chống lại tình trạng kháng thuốc kháng sinh.
Nghiên cứu do các nhà khoa học từ Trường Hóa sinh, Miễn dịch và Viện Khoa học Y sinh Trinity (TBSI) tại trường Đại học Trinity College Dublin thực hiện và vừa được công bố trên tạp chí quốc tế hàng đầu Nature Communications .
Lipoprotein và vai trò của chúng trong nhiễm trùng do các chức năng đa dạng của vi khuẩn Lipoprotein trong tế bào vi khuẩn. Một số cần thiết cho sự sống còn trong khi một số đóng vai trò quan trọng bằng cách tham gia vào phản ứng miễn dịch bẩm sinh của vật chủ.
Danh sách ngày càng tăng của các enzym có chức năng xây dựng lipoprotein bao gồm Lit (lipoprotein intramolecular transacylase) được phát hiện gần đây, tạo ra một loại lipoprotein cụ thể "làm mát phản ứng miễn dịch" - tăng khả năng Lit cho phép vi khuẩn có chỗ đứng trong vật chủ bằng cách tàng hình. Với mục đích tìm hiểu cách thức hoạt động của Lit ở cấp độ phân tử, nhóm do Trinity dẫn dắt vừa tạo ra cấu trúc tinh thể có độ phân giải cao, quan trọng nhất của Lit từ Bacillus cereus — một loại vi khuẩn thông thường được tìm thấy trong đất và thực phẩm.
Kết hợp với các kỹ thuật phân tích khác, mô phỏng động lực học phân tử và các phương pháp tiếp cận cơ học lượng tử, nhóm nghiên cứu hiện đã hiểu chi tiết về cách thức hoạt động của chúng.
Giáo sư danh dự Martin Caffrey (Trinity và TBSI), là tác giả chính của nghiên cứu, nhấn mạnh tầm quan trọng và tác động xã hội tiềm tàng của nó, ông nói: "Chúng tôi tin rằng Lit rất có thể là một yếu tố độc lực, tác động tiêu cực đến phản ứng miễn dịch của vật chủ đối với sự lây nhiễm. Vì vậy, nó có thể trở thành mục tiêu quan trọng cho việc phát triển các loại kháng sinh cực kỳ cần thiết chống lại sự kháng thuốc. Không quá lời khi nói rằng kháng kháng sinh là mối đe dọa thực sự ngày càng tăng đối với xã hội của chúng ta. Với cấu trúc tinh thể có độ phân giải cao và nền tảng vững chắc để hiểu cách thức hoạt động của nó trong tế bào vi khuẩn, chúng tôi đang ở vị trí như cách đây bốn năm khi chúng tôi công bố công trình nghiên cứu tương tự liên quan đến một enzym xử lý lipoprotein liên quan, được gọi là peptidase tín hiệu lipoprotein II (hoặc LspA). LspA hiện đang được giám sát chặt chẽ như một mục tiêu kháng sinh của một số nhóm nghiên cứu - bao gồm cả chúng tôi tại TBSI và một số công ty dược phẩm".
Trường Đại học TruTrinity College Dublin
Đỗ Quyên dịch
Lab Manager- Hoa Kỳ


Gợi mở về vai trò của diêm tiêu Việt Nam trong lịch sử thế giới

Thiết kế pin mới giúp giảm nguy cơ cháy nổ

JASIS 2025 – Triển lãm thiết bị khoa học và phân tích hàng đầu châu Á

Cấp thiết sửa đổi quy chuẩn kỹ thuật quốc gia cho sản phẩm sữa chế biến

Kiểm tra, xác nhận giá trị sử dụng phương pháp; ước lượng độ không đảm bảo đo lĩnh vực sinh học

Đảm bảo chất lượng kết quả thử nghiệm

Nhận thức chung ISO/IEC 17025:2017 và đánh giá nội bộ

Xác nhận giá trị sử dụng phương pháp thử trong phân tích hóa học

Triệt để tránh tình trạng “dễ làm, khó bỏ” trong nghiên cứu khoa học

Báo động: Vi nhựa xâm nhập não người với tốc độ nhanh













